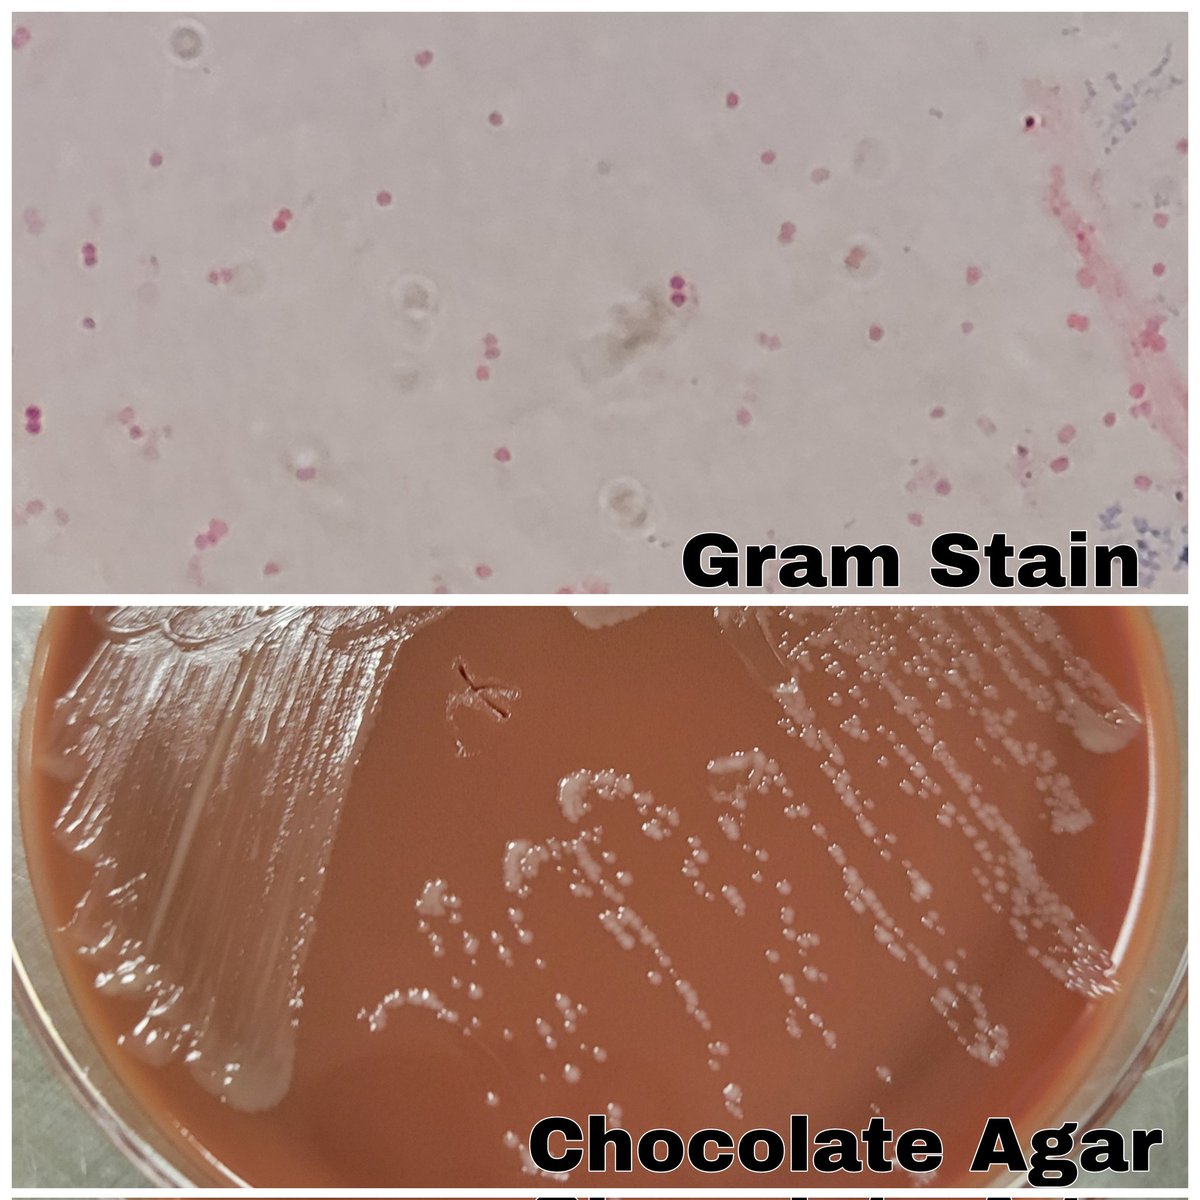
Julia Hankins, PhD, D(ABMM) tweet media

genovefa papanicolaou
49 posts


genovefa papanicolaou
@GenPapaMD
Transplant ID physician Memorial Sloan Kettering Cancer Center
New York, NY Beigetreten Eylül 2021
127 Folgt326 Follower

I feel deeply honored to receive the 2025 Dr. Josef Steiner Cancer Research Award for our work on decoding and rewiring the immune-evasive TME. It truly is a recognition of the entire team past and present as well as our collaborators and my mentors.🙌 Thank you for your trust.
IMP@IMPvienna
Congratulations to our @obenaufa on receiving the highly prestigious Dr. Josef Steiner Cancer Research Award 2025! 🎉 Read more in this interview with Anna: imp.ac.at/news/article/a…
English

Don’t miss the upcoming ASTCT webinar on RSV vaccines and monoclonals
#tab-product_tab_overview" target="_blank" rel="nofollow noopener">learn.astct.org/products/rsv-v…
English

ASTCT RSV guidelines now on line authors.elsevier.com/sd/article/S26…
@ASTCT_Journal A special shout-out @FirasElChaer for driving this to the finish line! @MichaelGIsonMD @ChemalyRoy @HansHHirsch1
English

Thank you @A_Spallonii . It is a real honor and privilege to be selected to lead such a great department at The #1 cancer institution!!! @MDAndersonNews. We still have a long road ahead of us to make a difference in the life of the most vulnerable patients that we care for!
Bellaire, TX 🇺🇸 English

FAQ on monkeypox finally in print! astctjournal.org/article/S2666-…
🙌@A_Spallonii @PergamIC, Emily Fordham @DadwalSanjeet
English
genovefa papanicolaou retweetet

Latest from our team! Led by one of our fantastic senior MLS, Brenden Clark as part of his MPH 💪🏽! NPI implemented in NYC in March 2020 resulted in decrease incidence of all respiratory viruses except Adeno 🤔 @MelviliCintron @mini_kamboj @MSKPathology #climicro #LabMedTwitter
English

Intestinal microbiota transplant (IMT) a cure for microbiological headache! Fantastic talk by Julian Marchesi from the imperial college, London UK #IDSymp23 , @HutchIDScience
English

Fantastic talk by @JimBoonyaratana on monoclonal Ab at #IDSymp23
English

Great work by @JoshuaHillMD and colleagues @ASTCT_Journal , @Astct, mentioned by Janet Englund #IDSymp23
English

Great work by @JoshuaHillMD on COVID19 vaccines in HCT mentioned by Janet Englund at #IDSymp23 @ASTCT_Journal @ASTCT
English

Fascinating talks on immune aging by Shernan Holtan, Noha Sharafeldin, Shahinaz Gadalla MD#MSKToxTCT
English

Join the ID-SIG journal club @ASTCT 👇
learn.astct.org/products/astct…
English

April 2023 Journal Club
Wednesday, April 19 | 2 PM – 3 PM CT learn.astct.org/products/astct…
English
genovefa papanicolaou retweetet

In the latest episode of ASTCT Talks, @GenPapaMD sits down with Dr. Richard O’Reilly & Prof. Karl Peggs to discuss the safety, challenges & opportunities around Virus-Specific T-Cells. Listen now on Spotify or wherever you get your podcasts: ow.ly/h4po50NI7Fy #CartTcells

English
genovefa papanicolaou retweetet

Don’t miss our hybrid symposium at #ECCMID2023 tomorrow, April 18, 2023 at 09:00 CEST on the management of resistant or refractory CMV with @GenPapaMD @HansHHirsch1 @HumarAtul and @ChemalyRoy! #RMEI
RMEI.com/CMV-18-April

English